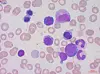

FAG i praksis

Kasuistikk: Innlagt med lav hemoglobinverdi, men med svært ulike diagnoser
Innlagt med lav hemoglobinverdi, men med svært ulike diagnoser.pdf(167 KB)
Ved Avdeling for medisinsk biokjemi, Diakonhjemmet Sykehus, analyseres daglig prøver fra pasienter med anemi av ulik grad og årsak. Noen får blodtransfusjon straks, mens andre får behandling først når den bakenforliggende årsaken til anemien er kjent. Det legges en utredningsplan, og bioingeniører bidrar med å analysere ulike parametere og videresender til spesialanalyser.
Bioingeniører får imidlertid sjelden vite noe om resultater og konklusjoner etter utredningen.
I disse to kasuistikkene har vi fulgt pasientene helt fram til diagnose og behandling. Det er interessant å se at pasienter som kommer inn med forholdsvis like verdier på en rekke analyser, får to helt ulike diagnoser.
To pasienter kommer inn i akuttmottaket med markert anemi og mistanke om malign sykdom:
- Kasus 1: Hb = 6,3 g/100 mL, SR = >140 mm/time, MCV= 119 fL og haptoglobin <0,1 g/L.
- Kasus 2: Hb = 6,9 g/100 mL, SR = 104 mm/time, MCV= 100 fL og haptoglobin <0,1 g/L.
Kasus 1: Vitamin B12-mangel
Pasienten er kvinne og 50 år. Hun er i full jobb og jogger vanligvis jevnlig. Hun blir imidlertid gradvis slappere i løpet av sommeren. Hun merker under en løpetur cirka to uker før innleggelsen at hun ikke har krefter igjen. Hun har et vekttap på fire kilo og forteller at mye mat har mistet smak eller smaker annerledes, og hun innlegges på grunn av lav Hb og mistanke om malign sykdom.
Innkomstverdiene viser klassisk B12-mangel med uttalt anemi, markert makrocytose, pancytopeni, lave retikulocytter og B12 er 40 pmol/L (referanseområde 140 - 600 pmol/L).
I perifert blod er det funn av hypersegmenterte nøytrofile granulocytter og kjerneholdige røde blodceller. LDH er 1830 U/L (referanseområde 105 - 205 U/L). Høy LD er en uspesifikk indikator på celleskade og megaloblastanemi. Lav haptoglobin finnes ved alle former for økt hemoglobinomsetning i organismen (hemolyse og ineffektiv erytropoiese).
Støtteverdier:
Benmargsaspirat viser livlig erytropoiese og megaloblastært bilde forenlig med B12-mangel.
Erytropoietin er 61,6 IE/L og er forhøyet som en reaksjon på anemien (referanseområde: 2,8 - 30,0 IE/L).
Homocystein er 101 μmol/L (referanseområde: 5 - 15umol/ L). B12- mangel fører til opphopning av homocystein intracellulært og gir økt homocystein i plasma.
Metamalonsyre er 6.9 pmol/L (referanseområde: <0,30 pmol/L). Stigning i metamalonsyre indikerer intracellulær eller funksjonell mangel på vitamin B12 (se tabell 1).

Behandling
Pasienten gis behandling etter standardprosedyre: Dag 1: B12-substitusjon startes, det gis deretter ukentlige injeksjoner tilsammen fem ganger. Deretter gis det B12-injeksjon hver tredje måned.
Generelt om megaloblastær anemi
B12- eller folinsyremangel er den hyppigste årsaken til MCV-verdier > 120 fL.
B12 og folinsyre deltar hver for seg eller sammen i en lang rekke kjemiske prosesser i kroppen, blant annet DNA-syntesen. Sviktende DNA-syntese fører til anemi. Selv om DNA-syntesen foregår langsomt, foregår syntesen av RNA, og dermed av proteinene, normalt. Cytoplasma modnes normalt, mens kjernen henger etter. Det blir færre celledelinger enn normalt, og resultatet er store celler. Granulocyttene som frigjøres er også preget av den defekte DNA-syntesen. Overflødig kjernemateriale avsnøres som ekstra kjernesegmenter. Anemien er fullstendig reversibel ved tilførsel av de manglende vitaminene.
Også nervesystemet trenger vitamin B12. Myelinkjedenes metabolisme forstyrres ved B12-mangel, og disse skadene kan være irreversible.
Årsak til B12-mangel
Feilernæring på grunn av malabsorbsjon er den vanligste årsaken til B12-mangel, men tilstanden sees også hos vegetarianere og personer med medfødte forstyrrelser eller mangel på intrinsic factor. Opptaket av vitamin B12 i tarmen er avhengig av intrinsic faktor som skilles ut fra celler i magesekken. Mangel på intrinsic faktor kan derfor føre til perniciøs anemi. Normalt har kroppen tilstrekkelig lagre av B12 til tre - fem års forbruk.
Mangel på B12 forsøkes kompensert ved økt hematopoietisk aktivitet, særlig av erytrocytter. I tillegg sees nedbrytning av cellene i sene cellestadier. I blodutstryk vil en kunne se venstreforskyvning i alle cellerekkene (1, 2).
Kasus 2: Hemolyse med varmeantistoffer
Kvinne 60 år innlegges av fastlege for utredning av anemi med spørsmål om underliggende malignitet. Pasienten har en fire ukers lang sykehistorie med hoste og økende slapphet, de siste to ukene også makroskopisk hematuri. Siste dager har hun hatt økende svimmelhet, noe tung pust og ødemer i underekstremiteter. Pasienten har redusert matlyst, kvalme og munntørrhet.
Blod er sendt til pretransfusjonsundersøkelse, men man avventer transfusjon da pasienten er klinisk kjekk, og siden anemien har kommet over tid. Man prioriterer å sikre god diagnostikk først.
Innkomstverdiene er forenlig med anemi og hemolyse. Høyt antall retikulocytter reflekterer livlig erytropoiese og som igjen fører til høy MCV. En finner lav haptoglobin ved alle former for økt hemoglobinomsetning, også ved hemolyse.
I tillegg ble det gjort en del serologiske undersøkelser. Cytomegalovirus IgG og IgM var positive. Det ble dessuten påvist mykoplasmainfeksjon før innleggelsen.
Diagnose: Pasienten får diagnosen «hemolyse med varmeantistoffer utløst av mykoplasmainfeksjon». Klinikk, funn og behandlingsrespons er forenlig med dette. Vanligvis er hemolyse med kuldeantistoffer assosiert til mykoplasmainfeksjon, men denne pasienten har varmeantistoffer og er dermed et unntak.
Hemolyse påvises og følges ved å måle hemolyseparametere som LD, bilirubin, haptoglobin og antall retikulocytter (se tabell 2).

Påvisning av autoimmun patogenese baserer seg på direkte antiglobulintest (DAT) og påvisning av autoantistoff i serum.
Behandling
Pasienten får behandling etter standardprosedyre: Dag 3 etter innleggelse startes høydoserte steroider, som nedtrappes gradvis etter at effekten er oppnådd.
Etter fire måneder er hemolysen gått fullstendig tilbake og blodverdiene er normalisert. IgG subgruppeanalyse viser normale forhold.
Autoimmune hemolytiske anemier (AHIA)
Autoimmun hemolyse initieres ved at et autoantistoff av varme- eller kuldetype bindes til et antigen på erytrocyttoverflaten. Et varmeantistoff har størst affinitet til antigenet ved 37oC.
Et kuldeantistoff har temperaturoptimum ved 4oC, men kan også reagere i et varmere miljø.
Insidensen av autoimmun hemolytisk anemi er beregnet til cirka én per 100 000 innbyggere per år hos voksne, og hos cirka 75 prosent er sykdommen utløst av varmeantistoffer. Årsaken er et dysregulert immunsystem med redusert evne til å skille mellom eget og fremmed, noe som igjen kan føre til autoimmun hemolytisk anemi med varmeantistoffer.
Hemolyse påvises og følges med hemolyseparametere som forhøyet LD og bilirubin i serum, redusert haptoglobin i serum og økt antall retikulocytter i blod. Videre sees positiv antiglobulintest (DAT), og det påvises autoantistoff i serum.
Vanligvis er autoantistoff av immunglobulinklasse IgG. IgA-autoantistoff forekommer oftest i kombinasjon med IgG. IgM forekommer sjeldnere.
Steroider er førstelinjebehandling og splenektomi annenlinjebehandling (3, 4).

Konklusjon
Ved hjelp av disse to pasientene har vi forsøkt å belyse at pasienter med ganske like innkomstverdier kan ha to helt forskjellige diagnoser. Begge hadde markert anemi og mistanke om malignitet ved innkomst. Den ene pasienten hadde klassisk B12 -mangel. Den andre hadde AHIA med varmeantistoff. Bioingeniører vet vanligvis ikke noe om den videre utredningen og behandling av pasientene, men slik kunnskap gjør jobben vår mer spennende.